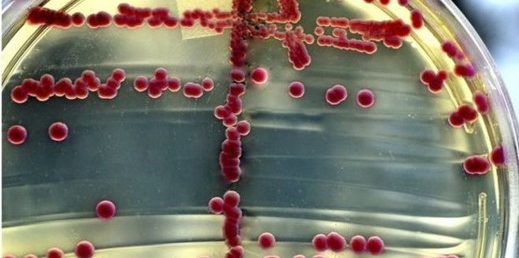

Süper bakteriye karşı kullanılan 26 antibiyotik de işe yaramadı
 Gereksiz antibiyotik kullanımı sebebiyle bakteriler giderek güçleniyor. Bilinen tüm ilaçlara dirençli bakterilere bir yenisi daha eklendi. Hindistan kaynaklı bakteriyi hiçbir ilaç öldüremiyor. Hindistan kaynaklı yeni bir süper bakteri tıp dünyasını çaresiz bıraktı. Nevada’da yaşyan ve Hindistan’ı ziyaret ettikten sonra hastalanan 70’li yaşlardaki ABD’li kadın, tüm müdahelelere rağmen kurtarılamadı. Tam 26 farklı antibiyotiği deneyen doktorlar hiçbirinin bakteriye etki etmediğini ve kadının eylül ayında hayatını kaybettiğini açıkladı.
Gereksiz antibiyotik kullanımı sebebiyle bakteriler giderek güçleniyor. Bilinen tüm ilaçlara dirençli bakterilere bir yenisi daha eklendi. Hindistan kaynaklı bakteriyi hiçbir ilaç öldüremiyor. Hindistan kaynaklı yeni bir süper bakteri tıp dünyasını çaresiz bıraktı. Nevada’da yaşyan ve Hindistan’ı ziyaret ettikten sonra hastalanan 70’li yaşlardaki ABD’li kadın, tüm müdahelelere rağmen kurtarılamadı. Tam 26 farklı antibiyotiği deneyen doktorlar hiçbirinin bakteriye etki etmediğini ve kadının eylül ayında hayatını kaybettiğini açıkladı.
ABD Salgın Hastalıklarla Mücadele Merkezi, bakterinin içinde bulanan “metalo-beta laktamaz” adlı enzimin, bilinen tüm ilaçları etkisizleştirdiği ortaya çıkardı. Antibiyotik kullanımının giderek artmasıyla, bakteriler ilaçlara her geçen gün direnç kazanıyor. Geçtiğimiz aylarda ABD’de 4 kişide “MCR-1” adlı süper bakteriye rastlanmıl, çok büyük yan etkileri sebebiyle son çare olarak başvurulan “kolistin” adlı ilaç bile etkisiz kalmıştı.
https://www.medikalakademi.com.tr/wp-content/uploads/2016/06/felaketin-ayak-sesleri-antibiyotik-direnci.jpg
Tıp dünyası her geçen gün yeni antibiyotikler üreterek bakterilerle savaşmaya çalışıyor. Dünya Sağlık Örgütü ise “bazı hastalar için” ecza dolabında hiçbir şey kalmadı diyerek durumun ciddiyetine dikkat çekiyor.
YAZIYI PAYLAŞ

Gereksiz antibiyotik kullanımı sebebiyle bakteriler giderek güçleniyor. Bilinen tüm ilaçlara dirençli bakterilere bir yenisi daha eklendi. Hindistan kaynaklı bakteriyi hiçbir ilaç öldüremiyor. Hindistan kaynaklı yeni bir süper bakteri tıp dünyasını çaresiz bıraktı. Nevada’da yaşyan ve Hindistan’ı ziyaret ettikten sonra hastalanan 70’li yaşlardaki ABD’li kadın, tüm müdahelelere rağmen kurtarılamadı. Tam 26 farklı antibiyotiği deneyen doktorlar hiçbirinin bakteriye etki etmediğini ve kadının eylül ayında hayatını kaybettiğini açıkladı.
Gereksiz antibiyotik kullanımı sebebiyle bakteriler giderek güçleniyor. Bilinen tüm ilaçlara dirençli bakterilere bir yenisi daha eklendi. Hindistan kaynaklı bakteriyi hiçbir ilaç öldüremiyor. Hindistan kaynaklı yeni bir süper bakteri tıp dünyasını çaresiz bıraktı. Nevada’da yaşyan ve Hindistan’ı ziyaret ettikten sonra hastalanan 70’li yaşlardaki ABD’li kadın, tüm müdahelelere rağmen kurtarılamadı. Tam 26 farklı antibiyotiği deneyen doktorlar hiçbirinin bakteriye etki etmediğini ve kadının eylül ayında hayatını kaybettiğini açıkladı. Çocuklarda antibiyotik kullanımı, ailenin bilgi ve tutumu
Çocuklarda antibiyotik kullanımı, ailenin bilgi ve tutumu Antibiyotik nedir, nasıl kullanılır? Faydaları, direnci ve zararları
Antibiyotik nedir, nasıl kullanılır? Faydaları, direnci ve zararları Antibiyotik direncini önlemek için tedaviye bilimsel veri sağlanarak çözüm aranmalı
Antibiyotik direncini önlemek için tedaviye bilimsel veri sağlanarak çözüm aranmalı Hindistan cevizi yağı neye iyi gelir? Faydaları nelerdir, nasıl kullanılır?
Hindistan cevizi yağı neye iyi gelir? Faydaları nelerdir, nasıl kullanılır? Burun bakterilerini inceleyen bilim insanları, süper etkili antibiyotik keşfetti
Burun bakterilerini inceleyen bilim insanları, süper etkili antibiyotik keşfetti
YORUMUNUZ VAR MI?